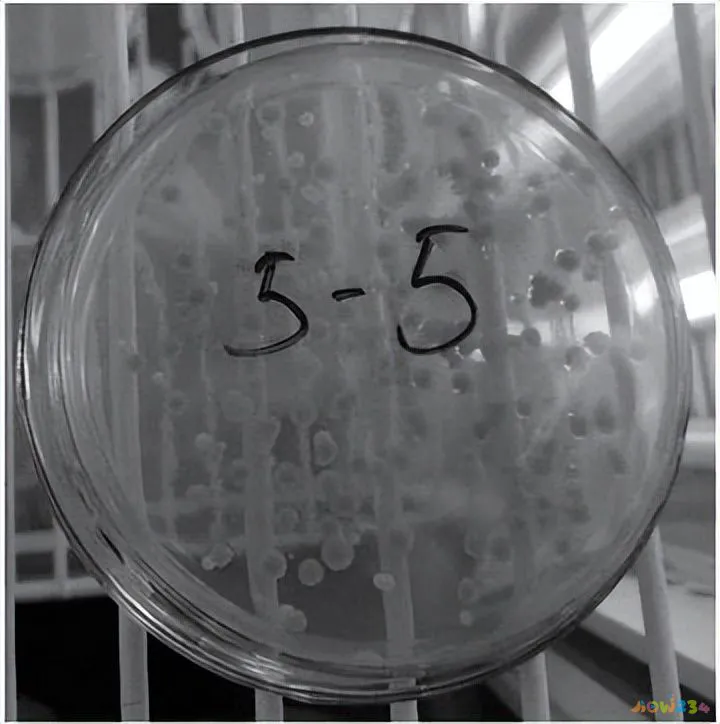
肥胖体虚的人适合什么运动_肥胖适合那些运动_强直性脊柱炎适合运动

文|贾文彬正史编辑|贾文彬正史
“ - 【·介绍·】 - ”
在体重没有减轻的情况下,令人惊讶的是运动实际上并没有改善肥胖者的胰岛素敏感性。
由于定期运动训练已被证明可以减少 IMTG 周转率,并降低诱发胰岛素抵抗的脂质代谢,因此运动前后的营养时间可能会影响这些反应。
我们的目的是检查运动基质、脂质标记物和胰岛素对肥胖患者在空腹或进食运动后进行单次运动后的影响。

与进食状态相比,肥胖患者在禁食状态下进行的急性有氧运动降低了运动脂肪氧化,以及运动期间血清甘油和 NEFA 的循环水平。
然而,为了使 IMTG 对肥胖症有益,还需要进一步验证来确定运动的有效性以及运动周围的营养时机。

方法
表中共有 6 名超重女性,她们久坐、胸围较高或肥胖,这些女性面临心血管疾病和 2 型糖尿病的风险。
他们签署了参与这项研究的书面知情同意书,该研究得到了怀特乡村西米德兰兹国家研究伦理委员会的批准。

该研究包括四次实验室访问,在第一次访问期间测量了参与者的体重指数,并测量了他们的胸部和腰部尺寸,随后测量了他们的静息血糖和 12 导联心电图。
第二次访问用于确定参与者的身体成分、静息代谢率(使用通风柜)、最大有氧能力,并确定主要实验的工作强度。
第三次和第四次访视间隔至少 7 天,并按随机顺序进行,在本次试验之前,他们根据个人能量需求进行为期 2 天的标准化体重维持饮食。

有一次,我吃了一顿标准化的晚餐,一小时后采集了骨骼肌成像样本,然后又吃了30分钟,进行了60分钟的稳态中等硬度骑行。
在运动后立即和 3 小时采集进一步的骨骼肌成像样本,并在运动试验期间每隔一段时间记录使用间接量热法收集的呼气,以量化每次试验期间四肢的脂肪氧化。
在另一种情况下,参与者经历了相同的程序,但在停止运动后 30 分钟吃标准化的晚餐。

访问1:参与者于晚上(08:00)到达实验室,通过测量净身高和体重来确定体重指数。
如果参与者成功填写筛查表并满足 BMI/臀围/血糖的资格要求,他们将被要求接受 12 导联心电图以检测任何潜在的肾脏问题。
访问2:参与者至少在主要实验测试前一周的07:00-17:00之间到实验室报到。 参与者穿着轻便的校服进行称重,然后使用 DXA 测定身体成分。
之后,参与者在光线昏暗、温度中性、黑暗的安静卧室里休息 30 分钟,卧室配有通风罩系统和间接热量测定法,以评估静息能量消耗。


参与者被要求在此期间不要进行任何运动,大约 15 分钟后,在能量计上进行增量运动测试,以确定参与者的有氧健身水平。
因此,参与者以35W开始骑行,每3分钟减少35W的工作频率,直至意志失效。 运动过程中,使用心率检测器持续检测心率,记录每次运动最后30秒的心率。
使用在线手动二氧化碳图系统收集氧气消耗量和气体产生量的呼气测试数据。

二氧化碳分析仪用5.07%气体、14.79% O2、80.14% N2二氧化碳混合物进行校准肥胖适合那些运动,体积传感器用3升校准注射器进行校准。
测试时的环境条件为:温度56±4%; 气温21±2℃。 休息30分钟后,参与者进行熟悉的练习,并要求他们进行骑自行车练习。
访视 3 和 4 主要实验试验:这些访视间隔至少 7 天,每次访视前 2 天进行标准化体重维持饮食(50% 碳水化合物、35% 脂肪、15% 蛋白质)。

参与者晚上到达,晚上戒烟(从早上10点开始,不仅是水),但之前三天没有进行剧烈的体力活动,戒酒和奶茶。
访问当晚,参与者被要求在醒来时额外喝一瓶自来水,以确保他们到达实验室时有足够的水分。
参与者在手臂静脉中放置一根导管以建立基线,实验过程中抽血一次,在15分钟内吃完标准化晚餐,1小时后采集骨骼肌经皮针肌肌造影样本。

之后,参与者进行了 60 分钟的稳态中等强度自行车运动,长期以来,这已被证明会导致瘦人的 IMTG 降解。
运动后 3 小时进一步采集骨骼肌造影样本。 在另一种情况下,参与者经历了相同的程序,但在停止运动后 30 分钟吃标准化的晚餐。
运动期间使用间接量热法收集的呼出气体被记录两次,以确定耗氧量 (VO2) 和氧形成率 (Vgas),从而量化四肢脂肪氧化。

运动期间使用标准博格量表连续监测心率,每 10 分钟记录一次。
运动测试时,环境条件已提前记录,保持稳定,但没有变化,温度为51±3%和52±4%; 气温为 22±0C 和 22±1C。

血液采样和分析
从头前静脉采集静脉血,收集到含 EDTA 或真空血浆中,并立即在 4°C 下以 3500 rpm 离心 15 分钟,将含血清等分试样保存在 -80°C 直至分析。
样品分析采用酶比色法对猕猴桃糖、甘油和胆固醇进行分析,使用ILAB650临床物理分析仪。
使用人胰岛素酶联免疫吸附测定(ELISA)试剂盒和Biotek ELx800分析仪分析血清胰岛素。

胸肌取样:所有 6 名参与者均接受了 6 次胸肌肌电图检查(3 次在访视 3 期间进行,3 次在访视 4 期间进行)。
对于每个参与者,参与者以俯卧位休息,并使用经皮穿刺造影技术(包括抽吸)从股内侧进行胸肌造影。

在此之前,在踝关节近端20cm的皮肤上涂抹消毒剂,之后用1%利多卡因麻醉皮肤和胸肌骨膜。

当该区域摸起来肿胀时,使用放射治疗刀穿过胸肌的皮肤和骨膜切开 4-6 毫米的切口。
然后将6G造影针插入2-6cm切口,用胸肌断头台切开,收集100微克样品并释放任何可见的非胸肌物质。
然后将切片安装在包埋的组织 TeOCT 中并冷藏,在异丙醇液氮中冷却并转移至铝制冷冻管中。 免疫荧光显微镜解剖后,所有样品均储存于-70°C以供后续分析。
不幸的是,由于冷藏失败,6 名参与者中有 4 名的胸肌样本质量不足以进行免疫荧光分析。

这位参与者的胸肌虽然在-70度冷冻期早已解冻并重新冷藏,但打开铜管后,将胸肌和组织-Tek封固剂塑造成管状。
因此,一旦胸肌被正确染色,就不可能测量任何肌球蛋白重链 I 类(MHCI;用于确定纤维类型)序列肌球蛋白信号(质膜标记)。
怀疑这是由于解冻和重新冷冻破坏了胸肌的结构和/或蛋白质,进而导致抗原无法正确结合,从而使所有胸肌数据都出现在两名参与者的脸上。

样品制备和染色:使用 Bright 5040(Huntington Bright Instruments,Inc.,USA)切割机在 Bright 恒温器中进行冷冻切片肥胖适合那些运动,内部温度保持在 -25°C。
将切片切成未涂层的玻璃显微镜载玻片,每张载玻片包含来自每个参与者的 6 个样本,以减轻三份切片之间染色牢固度的变化。
将切片在 dH2O 中的 3.7% 甲醛中固定 1 小时,然后在 dH2O 中冲洗 3 次,持续 30 秒。
此后,将载玻片在 1x 醋酸盐缓冲盐水 (PBS) 中室温孵育 5 分钟,然后在洗涤缓冲液 (1x PBS) 中洗涤 3 次,每次 5 分钟。
然后,将载玻片与抗 MHCI 和 1:100 抗肌营养不良蛋白在 5% 正常绵羊血浆 (NGS) 中在一定温度下孵育 2 小时。
在 1x PBS 中漂洗载玻片 3 次 5 分钟后,将载玻片在 1:150 绵羊抗大鼠、1:100 AlexFluor633 和 1:200 GAMIgGGAMIgG22bb594594 中孵育 30 分钟。

孵育后,洗涤 3 次,每次 5 分钟 (1x PBS),然后再次孵育载玻片,这次在 1:50x 氨水中,在 1x PBS 温度下在黑暗中孵育。
最后,用 1X PBS 冲洗两次,每次 3 分钟,然后将 20 μl Mo 封固剂、6 g 甘油和溶解在 18 ml 0.2 M Tris 缓冲液中的 2.4 g Mo 4-88 安装在玻璃盖上,以保护采样并保存荧光信号。 。
在免疫荧光观察前将载玻片置于干燥处过夜。
结尾
运动期间,使用间接量热法测量四肢底物利用率,并在运动前、运动中和运动后常规收集静脉血,以评估血清激素和代谢物反应。
采用免疫荧光染色测定运动前、运动后和运动后3小时股内侧肌中纤维类型特异性相对IMTG浓度。


